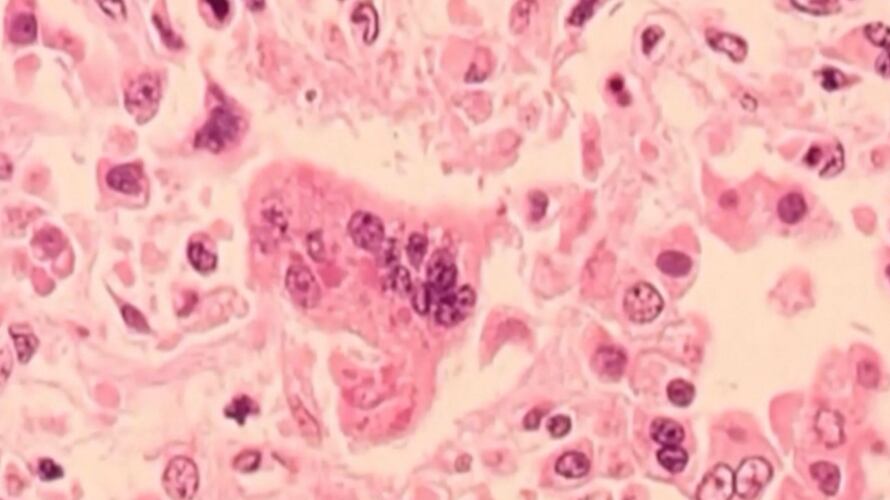

Le Québec fait face actuellement à sa deuxième éclosion de rougeole des 12 derniers mois.
Cette deuxième vague, entamée en décembre dernier est toujours en cours. Au moins cinq cas ont été déclarés en date du 30 décembre.
En Montérégie, deux lieux d'exposition à la maladie sont confirmés. Les deux à Saint-Bruno-de-Montarville.
Les gens qui se sont trouvés à Ski St-Bruno, samedi 4 janvier dernier entre 10h et 15h, doivent surveiller l'apparition de symptômes jusqu'au 25 janvier.
Pour ceux qui auraient visité le Supermarché Avril St-Bruno, également samedi 4 janvier dernier, entre 13h45 et 16h45, doivent, aussi, être aux aguets jusqu'au 25 janvier.
Les personnes à risque de complications sont les bébés de moins d'un an, les personnes dont le système immunitaire est affaibli et les femmes enceintes qui ne sont pas adéquatement vaccinées contre la rougeole.
La première éclosion de rougeole s’était produite au début 2024. Pas moins de 51 cas avaient été confirmés. Cette vague s’était terminée le 5 juin dernier.